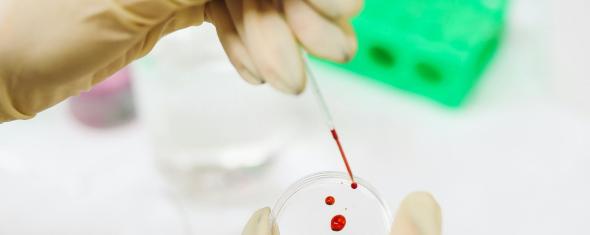

Polluants organiques persistants : le sang des volontaires des cohortes témoigne
Photo de Polina Tankilevitch. Libre utilisation.
Septembre 2024
Les polluants organiques persistants
Les polluants organiques persistants (abrégés en POP) forment un groupe hétérogène de substances chimiques. Beaucoup d’entre eux entrent dans la composition de plastiques, d’objets électroniques, de peintures, de textiles... D’autres sont utilisés en agriculture. Fruits d’activités humaines, ils finissent par être rejetés dans l’environnement.
Ils ont quatre caractéristiques : ils sont persistants, mobiles, bioaccumulables et toxiques. Persistants, ils se dégradent très lentement dans l’environnement, sur des dizaines, voire des centaines d’années. Très mobiles, ils sont présents partout et parfois loin de leurs points de rejet. Bioaccumulables, ils s’accumulent dans les tissus adipeux des organismes vivants et de ce fait, leur présence s’amplifie tout au long de la chaîne alimentaire. L’alimentation est d’ailleurs la principale source d’exposition aux POP, bien avant la pollution atmosphérique. Toxiques, les POP sont reconnus dangereux pour les écosystèmes et la santé humaine. En effet, plusieurs d’entre eux sont classés cancérogènes par le CIRC et sont soupçonnés d’agir comme des perturbateurs endocriniens (perturbation des systèmes hormonaux).
Réglementation
La gestion des risques liés à ces polluants appelle des réponses au plan national et international.
En France, la production et l’utilisation de polychlorobiphényles (PCB), mieux connus sous le nom de pyralène, sont interdits depuis 1987.
Dans le cadre des Nations Unies et de l’Union européenne, les deux textes majeurs sont le protocole d’Aarhus, dit protocole POP, signé en 1998 et la convention de Stockholm signée en 2001. Ces traités visent à réduire la production, l’utilisation et le rejet dans la nature (atmosphère, sols et eaux) des POP. Plusieurs classes de substances sont concernées, notamment : les dioxines et furannes, les pesticides organochlorés, les PCB, les polybromodiphényléthers (PBDE), et les substances per- et poly-fluoroalkylées (PFAS).
Objectifs de l’étude et méthodologie
Une étude menée dans l’équipe a permis d’établir, grâce aux échantillons de sang de femmes E3N collectés dans les années 1990, les niveaux de biomarqueurs des POP de ces femmes et de les comparer aux niveaux mesurés dans deux études françaises plus récentes. L’étude a également identifié des profils d'exposition aux POP et exploré leurs principaux déterminants.
Les chercheuses et chercheurs ont analysé 468 échantillons sanguins qui avaient été collectés auprès des femmes E3N entre 1994 et 1999 puis conservés congelés. Dans un second temps, l’équipe a comparé les résultats de ces analyses à ceux mesurés dans deux études françaises plus récentes menées par Santé Publique France : l’Étude Nationale Nutrition Santé (2006–2007) et l’étude Esteban (2014-2016).
73 biomarqueurs de POP ont été mesurés dans les échantillons des femmes E3N : 28 PFAS, 27 pesticides organochlorés, 14 PCB et 4 PBDE.
Résultats
Parmi les 73 biomarqueurs mesurés, plus de la moitié (41) ont été quantifiés chez plus de 75% des participantes E3N. Dans les études plus récentes, les niveaux de la plupart des polluants également mesurés ont diminué au fil du temps. « Cette tendance globale à la baisse est encourageante et marque un recul des niveaux d’exposition en France suite aux différentes mesures de protection prises par les pouvoirs publics. Toutefois il faut être très prudent sur l’interprétation fine des résultats, car les méthodes d’analyse ne sont pas identiques d’une étude à l’autre et les substances mesurées ne sont pas toujours les mêmes. En outre, certains produits de substitution à des POP désormais interdits n’ont pas été mesurés dans ces études : leur quantité dans le sang des Français pourraient avoir augmenté au cours des 10 à 20 dernières années », prévient Francesca Mancini.
Le travail effectué à partir de la cohorte E3N-Générations a par ailleurs permis d’identifier six différents profils caractérisés par l’exposition élevée à certains polluants. Des facteurs anthropométriques, socio-démographiques et d’habitudes de vie (notamment liées à l’alimentation) sont associés à ces différents profils.
Conclusion
Cette étude décrit pour la première fois le niveau d’exposition à un grand nombre de POP chez les femmes en France dans les années 1990 et permet de suivre leur évolution au cours des 20 années suivantes : la plupart des polluants pour lesquels une comparaison était possible ont diminué.
« Ce travail rappelle aussi l’importance de la participation des Français aux cohortes nationales pour poursuivre la biosurveillance et évaluer l’impact des polluants organiques persistants sur la santé », conclut Francesca Mancini.
Référence bibliographique :
Frenoy P, Cano-Sancho G, Antignac JP, Marchand P, Marques C, Ren X, Severi G, Perduca V, Mancini FR. Blood levels of persistent organic pollutants among women in France in the 90's: Main profiles and individual determinants. Environ Res. 2024 Oct 1:258:119468.




